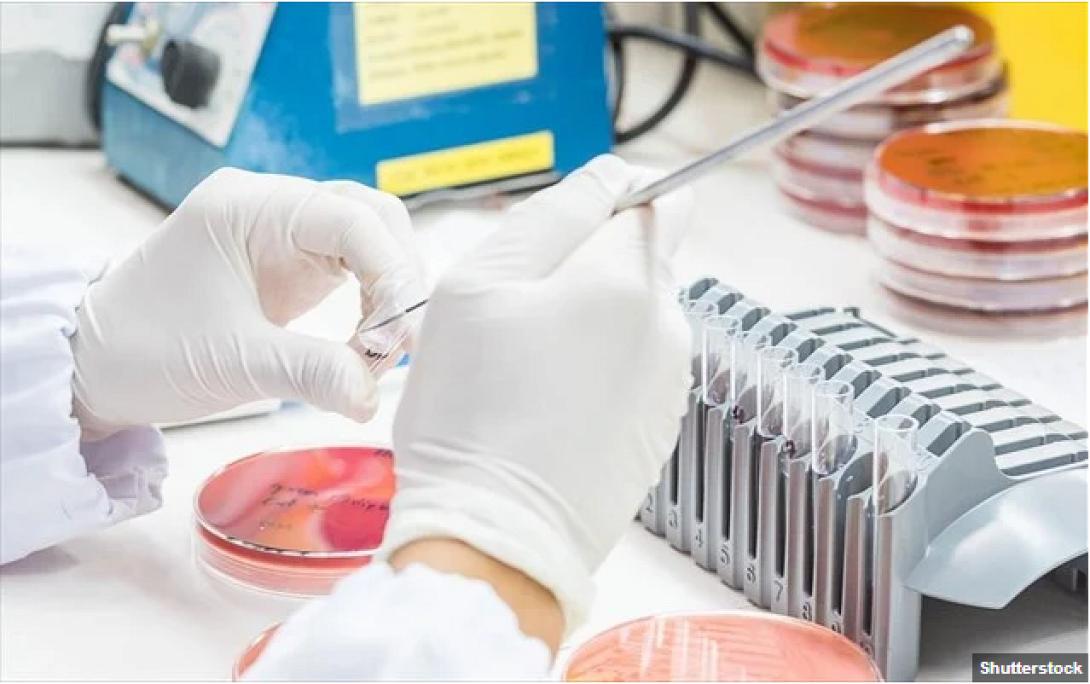
εργαστηριο

Η ιατρική κοινότητα περιμένει με αγωνία και πολλές ελπίδες περισσότερα στοιχεία για τα εντυπωσιακά αποτελέσματα της κλινικής δοκιμής του φαρμάκου Dostarlimab.
Στην κλινική δοκιμή συμμετείχαν 18 ασθενείς. Έλαβαν όλοι το ίδιο φάρμακο για έξι μήνες και μετά την ολοκλήρωση της δοκιμής και στους 18 η νόσος ήταν σε πλήρη ύφεση, με τους γιατρούς να μην μπορούν να βρουν σημάδια του καρκίνου στο σώμα τους.
Αν και το δείγμα είναι πολύ μικρό, για πρώτη φορά στα χρονικά έχουμε επιτυχία 100% ενός πειραματικού φαρμάκου. Και αυτό έχει εκπλήξει τους ερευνητές και έχει γεννήσει ελπίδες.
«Πιστεύω ότι είναι η πρώτη φορά που συμβαίνει κάτι τέτοιο στην ιστορία της νόσου του καρκίνου» δήλωσε στους New York Times ο δρ. Λούις Ντιάζ, εκ των ερευνητών που οργάνωσαν την κλινική δοκιμή και ογκολόγος στο Κέντρο Καρκίνου Memorial Sloan Kettering. «Είναι πραγματικά συναρπαστικό. Πρόκειται για μεγάλο βήμα προς τα εμπρός» πρόσθεσε ο Ντιάζ, ο οποίος συμμετέχει και στην Εθνική Συμβουλευτική Επιτροπή του Λευκού Οίκου για τον Καρκίνο.
Τώρα οι ερευνητές θα εξετάσουν κατά πόσο το φάρμακο μπορεί να έχει αποτέλεσμα και σε ασθενείς με άλλες μορφές καρκίνου. Ήδη βρίσκονται στα σκαριά κλινικές δοκιμές με καρκίνο του στομάχου, του προστάτη και του παγκρέατος.
ΔΙΑΒΑΣΤΕ ΕΠΙΣΗΣ
Βαριατρική χειρουργική: Αυξημένος ο κίνδυνος επιπλοκών για αυτούς τους ασθενείς
Σοβαρή κατάθλιψη: Αναποτελεσματική η ψυχοθεραπεία για όσους παίρνουν αντικαταθλιπτικά